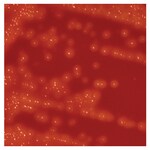
Quanti-Cult Plus&trade; Streptococcus pyogenes ATCC&trade; 19615&trade;

Search
Thermo Scientific™
Quanti-Cult Plus™ 化脓性链球菌 ATCC™ 19615™
通过新鲜富营养微生物培养基上生长的实际生物有机体获得快速和准确的微生物有机体鉴定。
| 货号 | 数量 |
|---|---|
| R4717000 | 100 次检测/试剂盒 |
货号 R4717000
价格(CNY)
-
数量:
100 次检测/试剂盒
Thermo Scientific™ Quanti-Cult Plus™ 化脓性链球菌 ATCC™ 19615™ 以一层保藏菌种膜(位于塑料小瓶的盖内侧)的形式提供,随时可以再水合并用于质控程序。
- 不要求连续稀释
- 提供单个 0.1 mL 接种物中 < 100 个菌落形成单位(colony forming units,以下简称 CFU)
- 10 次检测/重悬瓶;100 次检测/试剂盒
- 随时可以复溶
- 用于质量控制程序
包括:
10 个菌株保存瓶和 10 个再水合瓶。
*ATCC Licensed Derivative Emblem、ATCC Licensed Derivative 文字商标和 ATCC 目录商标均为 ATCC™ 的商标,并根据授权使用。
规格
ATCC®19615TM*
描述化脓性链球菌 ATCC™ 19615™
产品规格Quanti-Cult Plus
包装类型100 次检测/试剂盒
数量100 次检测/试剂盒
应变指示WDCM00013, Bruno [CIP 104226]
产品类型质控微生物
靶标有机物类球菌
测试类型定量 QC
Unit SizeEach